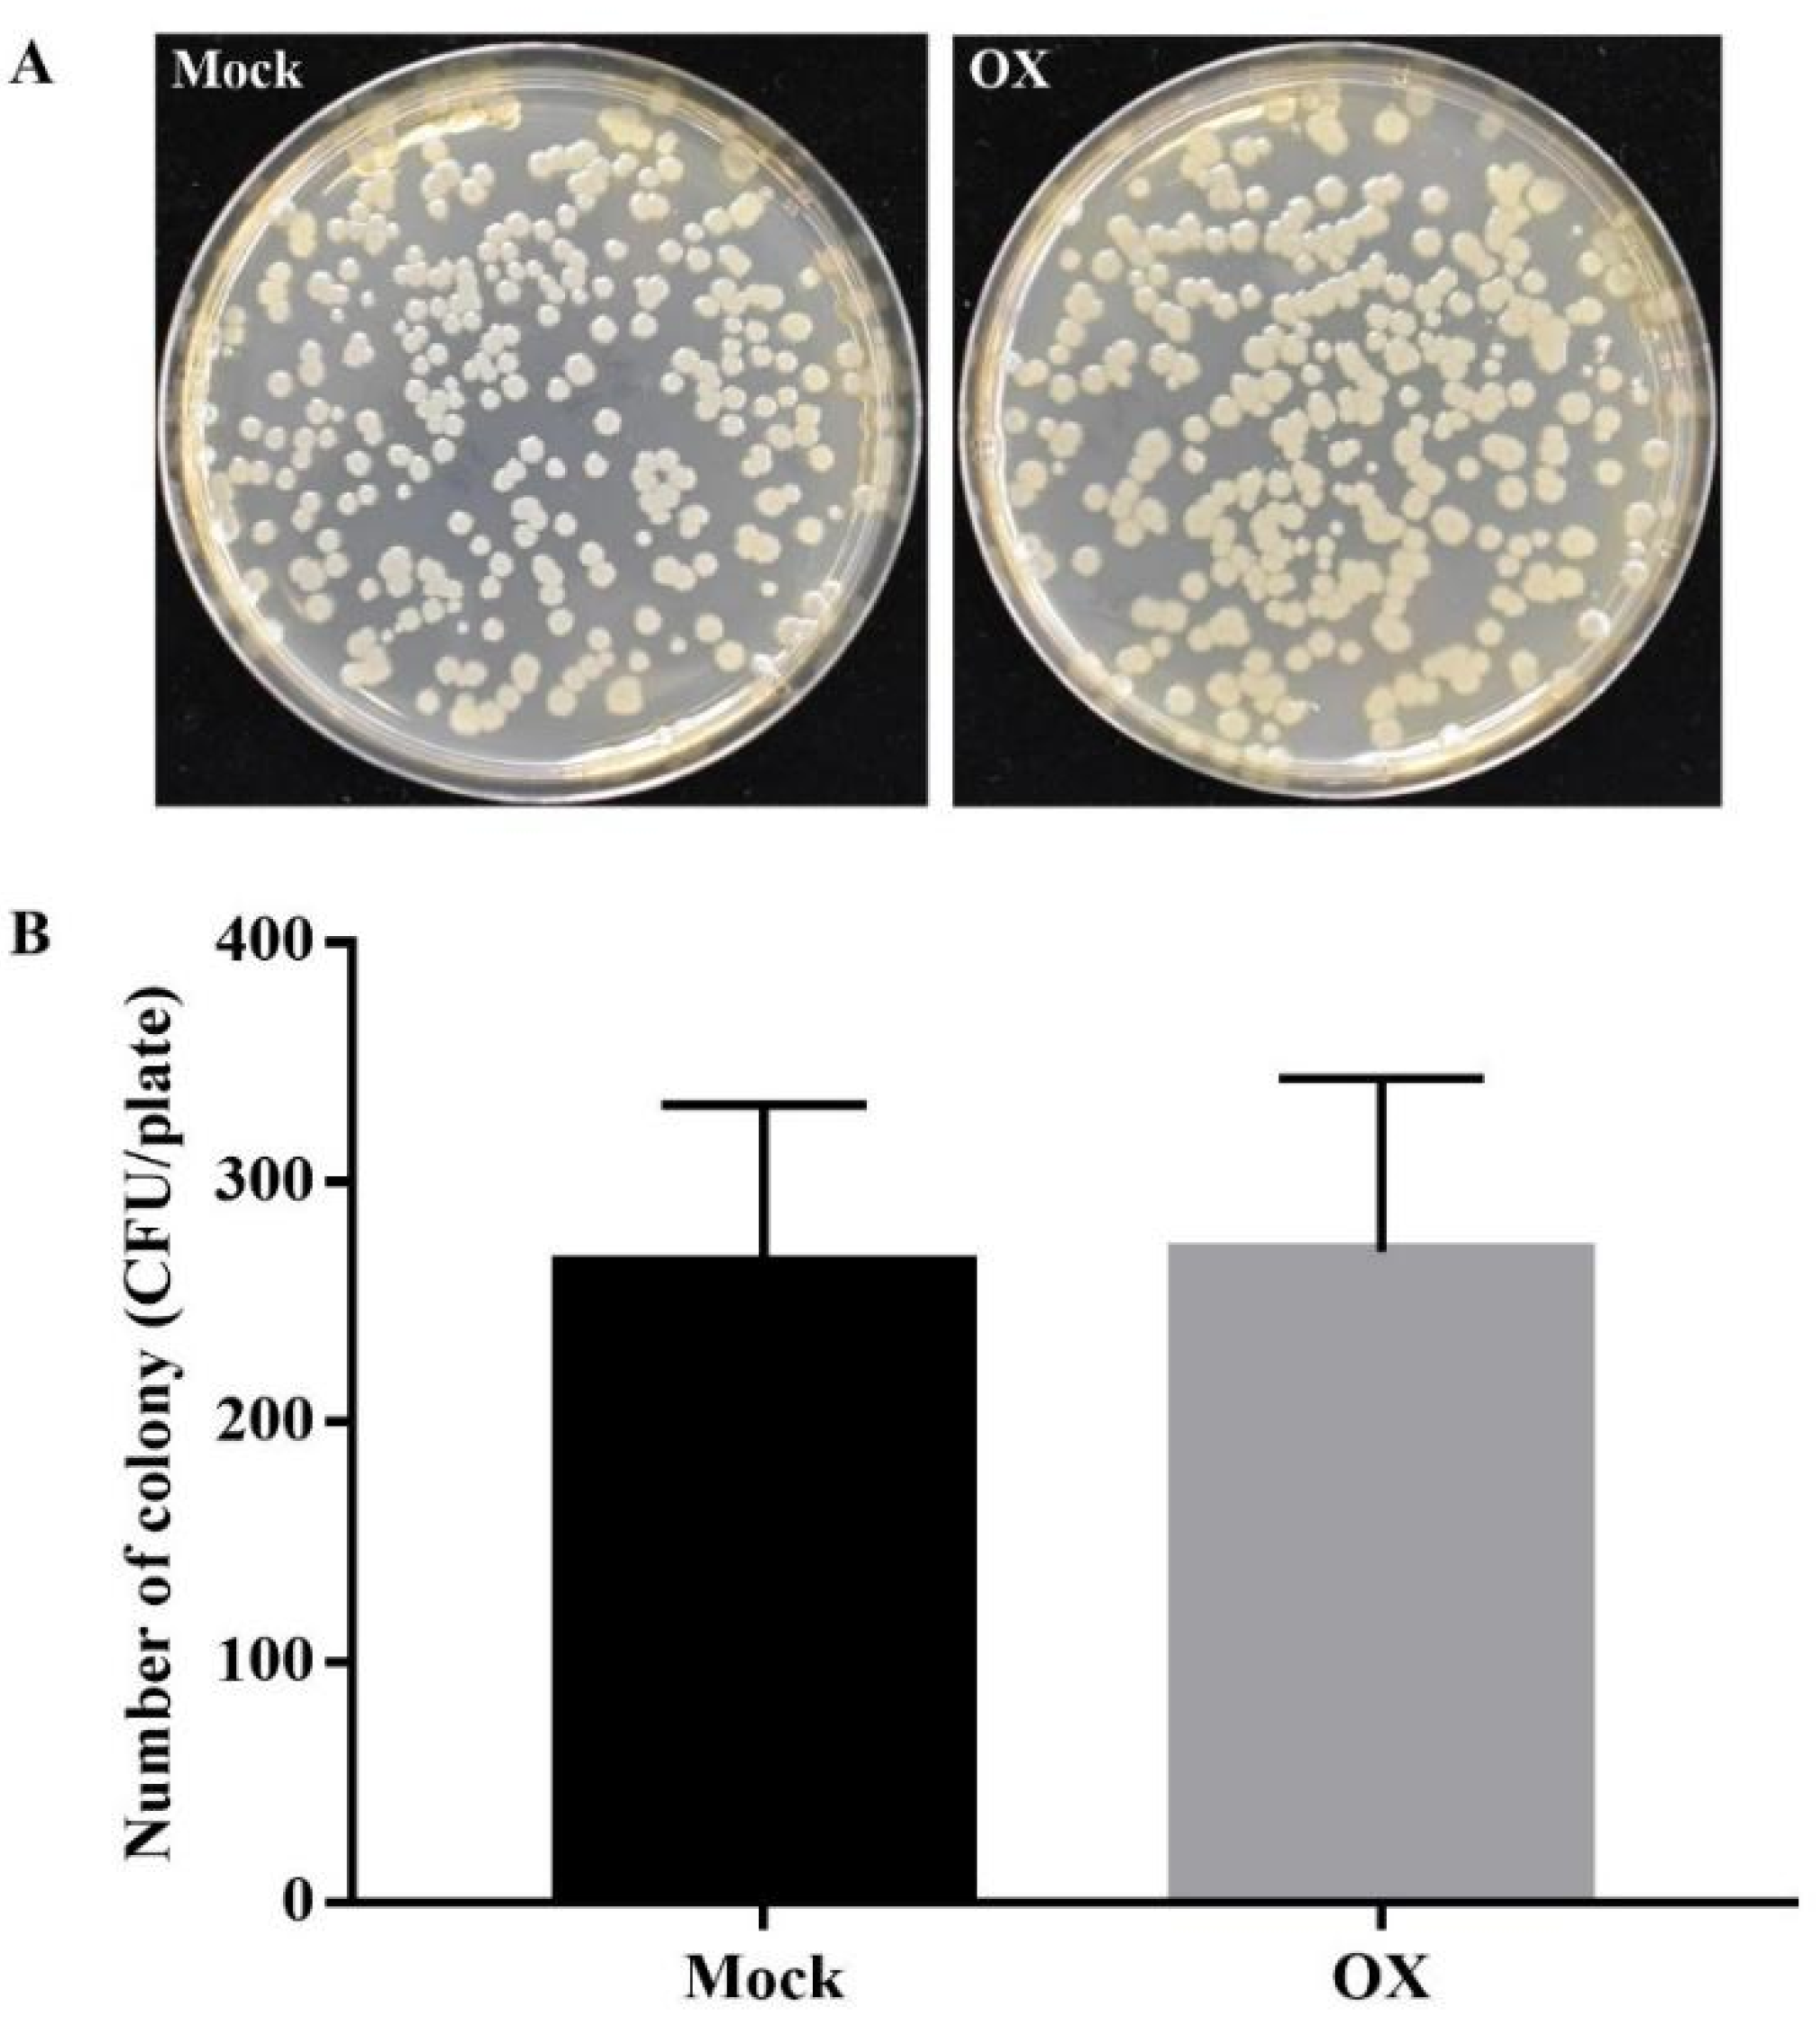
Ijms 21 01223 g002

Abstract
Oxathiapiprolin was developed as a specific plant pathogenic oomycete inhibitor, previously shown to have highly curative and protective activities against the pepper Phytophthora blight disease under field and greenhouse tests. Therefore, it was hypothesized that oxathiapiprolin might potentially activate the plant disease resistance against pathogen infections. This study investigated the potential and related mechanism of oxathiapiprolin to activate the plant disease resistance using the bacterium Pseudomonas syringae pv tomato (Pst) and plant Arabidopsis interaction as the targeted system. Our results showed that oxathiapiprolin could activate the plant disease resistance against Pst DC3000, a non-target pathogen of oxathiapiprolin, in Arabidopsis, tobacco, and tomato plants. Our results also showed the enhanced callose deposition and H2O2 accumulation in the oxathiapiprolin-treated Arabidopsis under the induction of flg22 as the pathogen-associated molecular pattern (PAMP) treatment. Furthermore, increased levels of free salicylic acid (SA) and jasmonic acid (JA) were detected in the oxathiapiprolin-treated Arabidopsis plants compared to the mock-treated ones under the challenge of Pst DC3000. Besides, the gene expression results confirmed that at 24 h after the infiltration with Pst DC3000, the oxathiapiprolin-treated Arabidopsis plants had upregulated expression levels of the respiratory burst oxidase homolog D (RBOHD), JA-responsive gene (PDF1.2), and SA-responsive genes (PR1, PR2, and PR5) compared to the control. Taken together, oxathiapiprolin is identified as a novel chemical inducer which activates the plant disease resistance against Pst DC3000 by enhancing the callose deposition, H2O2 accumulation, and hormone SA and JA production.
1. Introduction
Plants encounter numerous biotic and abiotic factors during their growth and development. Among the biotic factors, plant pathogens are the ones that cause many destructive plant diseases which result in substantial yield and economic losses [1]. However, plants have evolved a complex innate defense system to prevent the infections of diverse pathogens [2,3]. Two levels of immune responses, including the pathogen/microbe-associated molecular patterns (PAMPs/MAMPs) triggered immunity (PTI) and effector-triggered immunity (ETI), were well studied in the past decades [2,3,4]. PTI is the first-level protection of plants, which is activated via the perception and recognition of PAMPs/MAMPs by the pattern recognition receptors (PRRs) of plants [5]. Different MAMPs can activate PTI, but the defense responses have similarities, including the cytoplasmic Ca2+ changes, mitogen-activated protein kinases (MAPKs) activation, reactive oxygen species (ROS) burst, increased level of nitric oxide (NO), enhanced callose deposition, upregulated defense-related genes, and phytoalexin production [6,7]. Although plants are protected by PTI, many pathogens can successfully infect plants via the inhibition of PTI through their effectors. Therefore, during the battles between plants and pathogens, plants have evolved another layer of plant immunity, effector triggered immunity (ETI), to protect themselves from pathogen infections. ETI usually leads to the hypersensitive response (HR). HR can be induced via the recognition and counteraction of microbial effectors, such as by the plant nucleotide-binding leucine-rich-repeat (NB-LRR) proteins. ETI also includes the plant systemic acquired resistance (SAR) at the non-pathogen infected sites to confer long-lasting disease resistance against diverse pathogens through priming effects [2,3].
Plants can activate the plant immunity under a variety of environmental stimuli, such as the attack of avirulent pathogens, colonization of beneficial microbes, and application of chemicals [8]. The plant disease resistance activated by avirulent pathogens, chemical inducers, and beneficial microbes can enhance plant defense against different pathogens, such as oomycetes, fungi, bacteria, and viruses [9,10,11,12]. The plant resistance activated by avirulent pathogens and chemical inducers is usually associated with strong defense responses, such as the enhanced accumulation of salicylic acid (SA) and the increased transcripts of pathogenesis-related (PR) genes [12,13,14]. For the wild-type Arabidopsis (Col-0) plants, the pre-inoculation with the avirulent Pst strain can activate the plant disease resistance via the accumulation of SA and transcripts of PR1 [13]. Plant disease resistance can also be activated by the chemical inducers, such as SA, SA analog benzothiadiazole (BTH), and β-aminobutyric acid (BABA) [15]. Literature shows that the exogenous application of SA can induce plant disease resistance [16,17]. BTH can induce the plant disease resistance against many pathogenic infections in different plants, such as the Erysiphe graminis f. sp. tritici in Triticum aestivum [18], turnip crinkle virus, Peronospora parasitica and Pseudomonas syringae pathovar tomato (Pst) strain DC3000 (Pst DC3000) in Arabidopsis [19], Fusarium oxysporum f. sp. radicis-lycopersic in Solanum lycopersicum [20], and Botrytis cinerea in Vitis vinifera [21]. BABA, a nonprotein amino acid, can induce the plant disease resistance in many plants against different pathogens, such as the B. cinerea and P. parasitica in Arabidopsis [22,23], Plasmopara viticola in Vitis vinifera [24], and Colletotrichum gloeosporioides in Mangifera indica [25]. Plant disease resistance can also be activated by beneficial microbes. For example, the colonization of mycorrhizal fungus Glomus mossae in S. lycopersicum roots can activate the plant disease resistance against the pathogen Phytophthora parasitica [26,27].
Pseudomonas syringae (Pst) is a bacterial species widely used in studying the bacterial pathogenicity, plant–pathogen interactions, and pathogen ecology and epidemiology [28]. More than 50 pathovars have been identified in this species and each pathovar can infect a special group of host plants [28]. Collectively, the Pst pathovars can infect hundreds of different plants and result in diverse destructive diseases, including leaf spots and stem cankers [29]. The Pst strain DC3000 has the ability to infect both tomato and Arabidopsis plants, and its genome and genetic information have been well obtained [30]. Therefore, many researchers use this strain as a model to study the plant-bacteria interaction and the related disease resistance mechanism [31].
Oxathiapiprolin (OX), a piperidinyl thiazole isoxazoline fungicide, was synthesized by DuPont Company in 2007 [32,33]. OX was developed as an oomycete inhibitor with a high inhibition activity against many oomycetes, including Phytophthora capsici, Phytophthora infestans, Phytophthora sojae, Phytophthora parasitica, Phytophthora nicotianae, Pseudoperonospora cubensis, and Pythium ultimum [34,35,36,37]. Previous study showed that OX could interact with the oxysterol binding protein (OSBP) in oomycetes, which indicated that OSBP might be the target protein of OX [33]. Further study showed that in addition to the curative activity, OX also exhibited protective activity against the pepper Phytophthora blight under field and greenhouse tests [37]. Also, the protective activity of OX was better under the greenhouse conditions [37]. Because OX has better protective activity, we hypothesized that OX might have the potential to activate the plant disease resistance against the other pathogen infections in addition to oomycetes. To evaluate the potential function and investigate the related underlying mechanisms of OX in inducing plant disease resistance, the related experiments were conducted by mainly using the plant Arabidopsis and bacterium Pst DC3000 (a non-target bacterial pathogen of OX) interaction system. In addition, Nicotiana benthamiana (tobacco) and Solanum lycopersicum (tomato) were also utilized in the related study. For the outcome of the study, we identified that OX was a novel chemical inducer, which could activate the Arabidopsis plant disease resistance against Pst DC3000 through enhancing the callose deposition, H2O2 accumulation, and SA and JA accumulation.
2. Results
2.1. OX Induced the Plant Disease Resistance against Pst DC3000 Infection
To evaluate the potential role of OX in activating the plant disease resistance against the bacterial pathogen Pst DC3000, two types of treatments were designed and conducted. Firstly, the Arabidopsis plants were sprayed with OX (40 μg/mL) or mock (water with DMSO) to the leaves of the whole plants. Then the Arabidopsis leaves were challenged with the Pst DC3000 by the infiltration using a 1 mL syringe at two days after the pre-treatment of OX. The bacterial growth was examined at three days post infiltration (dpi). Compared to the mock plants, the Pst DC3000 growth was reduced significantly in the OX-treated plant leaves (Figure 1A). Furthermore, the lower three leaves of another set of Arabidopsis plants were firstly injected with OX (40 μg/mL) or mock (water with DMSO). Two days after the OX injection, the upper three or four Arabidopsis leaves were infiltrated with the Pst DC3000 with a 1 mL syringe. The bacterial growth was examined at 3 dpi. Compared to the mock plants, the Pst DC3000 growth was reduced significantly in the OX-treated plants (Figure 1B).
Figure 1.
OX activated the plant disease resistance against Pst DC3000 infection in Arabidopsis plants. (A) OX activated the plant disease resistance against the Pst DC3000 infection via the spray treatment. The Arabidopsis plants (Col-0) were firstly sprayed with OX (40 μg/mL) or mock (water with DMSO). Then the Arabidopsis leaves were infiltrated with the Pst DC3000 (1 × 105 Colony Forming Unit (CFU)/mL, OD600 = 0.0002) using a 1 mL syringe two days after the spray treatment. Three days after pathogen inoculation, the bacterial growth was quantified using the plate assay. (B) OX activated the plant disease resistance against the Pst DC3000 infection via pre-infiltration in local leaves. The lower leaves were pre-infiltrated with OX (40 μg/mL) or mock (water with DMSO) two days before the pathogen Pst DC3000 inoculation. The upper leaves were infiltrated with the Pst DC3000 (1 × 105 CFU/mL, OD600 = 0.0002) using a 1 mL syringe. Three days after the pathogen inoculation, the bacterial growth was quantified using the plate assay. Significant differences between the OX-treated plants and the mock were indicated by the asterisks determined from the Student’s t-test (p < 0.05). Results shown (means ± SD) are from one of the three independent repeats with the consistent results.
Besides, OX-induced plant disease resistance against the bacterial pathogen Pst DC3000 was evaluated in tobacco and tomato plants. The tobacco and tomato plants were sprayed with OX (40 μg/mL) or mock (water with DMSO) on the leaves of the whole plants. Two days after the pre-treatment, the tomato or tobacco leaves were challenged with the Pst DC3000 by the infiltration with a 1 mL syringe. The bacterial growth was examined at 3 dpi. Compared to the mock plants, the Pst DC3000 growth was reduced significantly in the OX-treated tobacco or tomato leaves (Figure S1A,B), which was consistent with the results in Arabidopsis.
To further confirm that the reduced growth of bacteria was due to the OX-induced plant disease resistance, the direct inhibition effect of OX against the Pst DC3000 was tested by the in-vitro plate assay. The results showed that OX had no direct inhibition effect against the Pst DC3000 (Figure 2A,B). All these results indicated that OX could induce the plant disease resistance against the Pst DC3000 in Arabidopsis, tomato, and tobacco plants.
Figure 2.
OX had no direct inhibition effect against the Pst DC3000 via the in-vitro plate assay. The direct inhibition effect of OX against the Pst DC3000 was performed by using King’s B agar amended with mock (DMSO) or OX (40 µg/mL). About 100 µL bacterial suspension (5 × 103 CFU/mL) was uniformly plated on the surface of the agar plate. The photos of the plates (A) were taken, and the colony number (B) was counted after 2 days of darkness-incubation at 28 °C. Three replicates were prepared for each treatment. Results shown (means ± SD) are from one of the three independent repeats with the consistent results.
2.2. OX Activated the Plant Disease Resistance by Enhancing the H2O2 Accumulation in Arabidopsis Plants
To investigate the underlying mechanism of OX-induced plant disease resistance, the H2O2 accumulation was compared between the mock and OX-treated Arabidopsis plants. For both real-time and total quantification of H2O2, there were no significant differences in the chemiluminescence accumulation between the mock- and OX-treated Arabidopsis without the flg22 treatment (a peptide corresponding to the most conserved domain of the bacterial flagellin, acting as a common and potent elicitor of PTI). However, the chemiluminescence accumulation was significantly increased in the OX-treated Arabidopsis plants with the flg22 treatment compared to the mock-treated ones (Figure 3A,B). The result indicated the enhanced ROS burst in the OX-treated Arabidopsis plants. Further experiments were conducted to quantify the gene expression level of the ROS related gene, such as the respiratory burst oxidase homolog D (RBOHD), which plays a crucial role in the accumulation of ROS in apoplast [38]. The qPCR result showed that the transcription level of RBOHD was not significantly changed between the mock- and OX-treated Arabidopsis plants before the Pst DC3000 treatment. However, the OX-treated Arabidopsis plants had significantly higher expression level of RBOHD than that of the mock-treated ones at 24-h post infiltration (hpi) with the Pst DC3000 (Figure 3C), which was consistent with the increased H2O2 accumulation in response to the flg22 treatment. All these results indicated that OX induced the plant disease resistance potentially by enhancing the H2O2 accumulation in Arabidopsis plants upon the pathogen Pst DC3000 inoculation.
Figure 3.
The OX enhanced H2O2 accumulation in Arabidopsis plants upon the flg22 or Pst DC3000 treatments. Wild-type Arabidopsis plants (Col-0) were sprayed with OX (40 μg/mL) or mock (water with DMSO). Two days later, the H2O2 accumulation in leaves was continuously detected for 30 min using the GLOMAX 20/20 luminometer (Promega). (A) The real-time chemiluminescence in the leaves and (B) total chemiluminescence in the leaves within 30 min of flg22 treatment. (C) The relative expression levels of RBOHD in mock- and OX-treated Arabidopsis leaves before and after the Pst DC3000 inoculation. ACTIN was used as the internal reference gene. Significant differences between the OX-treated plants and the mock were indicated by the asterisks determined from the one-way analysis of variance (ANOVA) statistical test using SPSS ver. 21 (p < 0.05). Results shown (means ± SD) are from one of the two independent repeats with the consistent results.
2.3. OX Activated the Plant Disease Resistance by Increasing the Callose Deposition in Arabidopsis Plants
To further investigate the underlying mechanism of OX-induced plant disease resistance, the callose deposition, which is an indicator of cell wall defense [39,40], was compared between the mock- and OX-treated Arabidopsis plants (Figure 4A,B). The callose deposition levels were low and similar between the mock- and OX- treated Arabidopsis plants with the water treatment. While the callose deposition was significantly increased in both the mock- and OX-treated Arabidopsis plants with the flg22 treatment. However, the callose deposition was significantly higher in the OX-treated Arabidopsis plants than the mock-treated ones after the flg22 treatment, indicating an enhanced cell wall-related defense response in the OX-treated Arabidopsis plants during the interactions with the bacterial pathogen.
Figure 4.
OX enhanced the callose deposition in Arabidopsis plants. Wild-type Arabidopsis plants (Col-0) were firstly sprayed with OX (40 μg/mL) or mock (water with DMSO). Then the Arabidopsis leaves were treated with water or 100 μM flg22 using the infiltration with a 1 mL syringe two days after the spray treatment. The leaves were then stained using 0.01% aniline blue for the callose deposition after 14–16 hpi of flg22 treatment. (A) The images of callose deposition in Arabidopsis leaves were taken by a Nikon Eclipse 80i epi-fluorescent microscope (Nikon, Tokyo, Japan). (B) The number of callose deposition points was counted by the Image J software. Significant differences between the OX-treated plants and the mock-treated plants were indicated by the asterisks determined from the Student’s t-test (p < 0.05). Results shown (means ± SD) are from one of the two independent repeats with consistent results.
2.4. OX Activated the Plant Disease Resistance by Enhancing both the SA and JA Related Pathways in Arabidopsis Plants
To further investigate the underlying mechanism of OX-induced plant disease resistance, the levels of several plant hormones in the mock- and OX-treated Arabidopsis plants before and after the Pst DC3000 inoculation were quantified (Figure 5). The levels of free SA and JA did not show significant differences in the mock- and OX-treated Arabidopsis plants without the challenge of Pst DC3000. However, compared to the mock-treated ones, both free SA and free JA levels were significantly higher in the OX-treated Arabidopsis plants under the challenge of the Pst DC3000 (Figure 5A,C). The levels of SA-Gly (glycosylated derivatives of salicylic acid), JA-Ile/Leu, and ABA had no significant differences in the mock- and OX-treated Arabidopsis plants with or without the Pst DC3000 inoculation (Figure 5B,D,E). The hormone results indicated that OX activated the plant disease resistance by enhancing the accumulation of both SA and JA.
Figure 5.
OX increased the levels of free SA and JA in Arabidopsis plants with the Pst DC3000 treatment. (A) Free SA level. (B) SA-Gly (glycosylated derivatives of salicylic acid) level. (C) Free JA level. (D) JA-Ile/Leu (JA-isoleucine/leucine) level. (E) ABA level. Wild-type Arabidopsis plants (Col-0) were sprayed with OX (40 μg/mL) or mock (water with DMSO). The Arabidopsis leaves were infiltrated with the Pst DC3000 (5 × 105 CFU/mL, OD600 = 0.001) with a 1 mL syringe two days after the spray treatment. The samples were collected for hormone quantification at 2 dpi. Significant differences between the OX-treated plants and the mock were indicated using the asterisks determined from the Student’s t-test (p < 0.05).
Further, the transcription levels of several typical genes in SA and JA related pathways were quantified. First, the transcription levels of SA-responsive genes were analyzed, including PR1, PR2, and PR5. Although SA accumulation did not differ significantly without the Pst DC3000 inoculation, the significantly higher transcription levels of PR genes were shown in the OX-treated Arabidopsis plants compared to the mock-treated ones, except PR2 (Figure 6A–C). Consistent with the hormone results, the OX-treated Arabidopsis plants had significantly higher expression levels of these three PR genes than the mock-treated ones at 24 hpi with the Pst DC3000 treatment (Figure 6A–C). Next, a typical JA-responsive gene PDF1.2 was analyzed, which is important for the defense against the necrotrophic pathogens [41]. The result showed that the expression level of PDF 1.2 was significantly higher in the OX-treated Arabidopsis plants than the mock-treated ones at 24 hpi with the Pst DC3000 treatment (Figure 6D), which was consistent with the JA accumulation. Consistent with the similar accumulation of ABA with or without the challenge of Pst DC3000, the transcription levels of two ABA related genes, ABI4 and ABA2, showed the similar levels in both the OX-treated and mock-treated Arabidopsis plants at 24 hpi with the Pst DC3000 inoculation (Figure 6E,F). Taken together, both SA- and JA-signaling pathways might contribute to the OX-induced plant disease resistance in Arabidopsis, while ABA might not be very important for the OX-induced plant disease resistance.
Figure 6.
OX enhanced the transcription levels of the SA- and JA-responsive genes in Arabidopsis plants with the Pst DC3000 treatment. Wild-type Arabidopsis plants (Col-0) were sprayed with OX (40 μg/mL) or mock (water with DMSO). The Arabidopsis leaves were infiltrated with the Pst DC3000 (1 × 105 CFU/mL, OD600 = 0.0002) with a 1ml syringe two days after the spray treatment. Samples for RNA extraction were collected and frozen in liquid nitrogen at 0 and 24 hpi. The relative transcription levels of PR1 (A), PR2 (B), PR5 (C), PDF1.2 (D), ABI4 (E) and ABA2 (F) were quantified by real-time qPCR. ACTIN was used as the internal reference gene. Significant differences between the OX-treated plants and the mock-treated plants were indicated by the one-way ANOVA statistical test by SPSS ver. 21 (p < 0.05). Results shown (means ± SD) are from one of the two independent repeats with the consistent results.
3. Discussion
OX was firstly synthesized as a fungicide to control oomycete-associated plant diseases by the DuPont Company in 2007 [32,33]. Previous research indicated that OX exhibited direct and high inhibition activity against the growth of many oomycete pathogens with a low dose. The target protein of OX was the oxysterol binding protein (OSBP) in oomycetes [33,34,35,36,37]. Besides, OX exhibited both curative and protective activity against pepper Phytophthora blight, and the protective activity was better [37]. There is no further study on the potential of OX to induce the plant immunity against the other pathogens in addition to oomycete pathogens. Therefore, in the present study, the related responses and mechanisms of the induced plant disease resistance by OX was investigated mainly using the Pst DC3000 and Arabidopsis interaction system.
The Pst DC3000 and Arabidopsis interaction system is widely used in studying the interactions of pathogens and hosts [42]. Here, we found that spraying the Arabidopsis plants with OX at the concentration of 40 μg/mL two days before the pathogen Pst DC3000 inoculation could enhance the Arabidopsis plant defense against the Pst DC3000. A further experiment showed that the infiltrated local leaves of Arabidopsis with OX could enhance the defense of the systemic leaves against Pst DC3000. Besides, spraying treatment of the plants with OX at 40 μg/mL could activate the plant disease resistance against the Pst DC3000 in tobacco and tomato plants. All these results indicated that OX could serve as a common inducer for plant immunity to activate the plant disease resistance against the Pst DC3000 infection in diverse plant species.
Reactive oxygen species (ROS) are widely distributed in plants under different conditions, including the challenges of both abiotic and biotic stresses. ROS are important factors to regulate the cellular process and signaling transduction in plants. ROS also play important roles in plant immune response against the pathogen infections [43]. Under the attack of pathogens, plants will activate defense responses, such as the oxidative burst to produce ROS at the infection site, which is one of the earliest events of a plant’s defense responses [44]. Various subcellular compartments of plants can produce ROS, including the mitochondria, chloroplasts, cell wall, plasma membrane, and peroxisomes/glyoxysome [43]. However, the apoplastic ROS, mainly produced at the plasma membrane, are considered as the major ones during the interactions of plants and pathogens [43]. The NADPH oxidases, a member of the respiratory burst oxidase homolog (RBOH) family, are very important in ROS production. They can transfer electrons from cytosolic NADPH or NADH to the apoplastic oxygen and finally involve in the production of hydrogen peroxide (H2O2) [43,44,45]. In Arabidopsis, there are 10 members of RBOHs, among which RBOHD is the most studied and plays an important role in plant immunity [38,45]. In this study, the levels of H2O2 were quantified using the Glomax 20/20 single-well luminometer (Promega), and the transcription level of RBOHD was quantified using real-time qPCR. Compared to the mock-treated Arabidopsis plants, the H2O2 accumulation and the transcription level of RBOHD were significantly increased in the OX-treated Arabidopsis plants with the flg22 treatment or the Pst DC3000 inoculation. The results indicated that the ROS burst may contribute to the OX-induced plant disease resistance.
The plant cell wall is one of the first barriers of plants to prevent themselves from the pathogen infections [46]. Plants can enhance the depositions of several polymers, such as employ the toxic compounds, phenolic complexes, and callose to defend themselves against pathogen infections [47]. Among these polymers, callose is a polymer with a high–molecular weight, and it consists of β-(1,3)-glucan, which can be induced by the PAMPs, such as flg22 [39]. The callose deposition is a judging method widely used to evaluate the plant PTI [39,40]. In this study, the callose deposition was visualized using the aniline blue staining based on the previous report [40]. Compared to the mock-treated Arabidopsis plants, the callose deposition was significantly higher in the OX-treated Arabidopsis plants under the induction of flg22, indicating a strengthened cell wall in the OX-treated Arabidopsis plants, which might contribute to the OX-induced plant disease resistance.
Plant hormones are important for the development and defense of plants. There are nine major plant hormones. Among them, salicylic acid (SA), jasmonic acid (JA), and ethylene (ET) are the main hormones to regulate plant immunity under different biotic and abiotic stresses [48,49]. These three main pathways could cross-talk with the other hormone pathways to confer resistance against diverse pathogen infections [48,49]. Generally, SA is associated with the plant defense against the hemi-biotrophic and biotrophic pathogens. In contrast, JA plays a more important role in plant defense against the necrotrophic pathogens [48]. The functions of SA and JA in plant immunity could be antagonistic [49,50]. However, literature has shown that SA and JA could cooperate with each other and function synergistically in plant immunity [51,52,53]. In general, to defend against the infections of the necrotrophic and biotrophic pathogens, ABA is a negative regulator in plants [49]. However, there is evidence showing that ABA could also be a positive regulator of plant defense, such as Arabidopsis plant resistance against the Pst DC3000 (a hemi-biotrophic pathogen) at the early stage, by inducing plant stomata closure [54]. Therefore, the exact function of ABA in plant defense should be determined by different plant-pathogen interactions at different infection stages [49].
Plant hormones are very important in plant defense. Whether the hormone pathways contributed to the OX-induced plant disease resistance remains unclear. In this study, we found that under the challenge of the Pst DC3000, both the free SA and JA levels were significantly increased in the OX-treated Arabidopsis plants than those of the mock-treated Arabidopsis plants at 48 hpi. The levels of SA-Gly, JA-Ile/Leu, and ABA had no significant differences in the mock- and OX-treated Arabidopsis plants. In addition, the real-time qPCR results showed that the OX-treated Arabidopsis plants had higher transcription levels of three PR genes, including PR1, PR2, and PR. The level of the JA-responsive gene, PDF 1.2, was also significantly enhanced compared to the mock-treated Arabidopsis plants. However, the plants showed similar transcription levels of two ABA signaling genes, ABI4 and ABA2. Taken together, we discovered that both SA and JA pathways were activated in the OX-treated Arabidopsis plants upon the Pst DC3000 inoculation, which indicated that both SA- and JA-signaling pathways might contribute to the OX-induced plant disease resistance in Arabidopsis and these pathways might work synergistically. However, the ABA pathway might not be significantly involved in the related plant disease resistance.
The mechanisms of the OX-induced and the BTH or BABA-induced plant disease resistance have similarities and differences. Literature shows that BTH or BABA can induce the plant broad-spectrum disease resistance [19,20,21,22,23,24,25]. For instance, BTH can induce the plant disease resistance against turnip crinkle virus, Peronospora parasitica, and Pst DC3000 in Arabidopsis [19]. BABA can induce the plant disease resistance against B. cinerea and P. parasitica in Arabidopsis [22,23]. For the present study, we found that OX could induce the plant disease resistance against the Pst DC3000 in Arabidopsis, tobacco and tomato plants. Whether OX could induce the plant broad-spectrum disease resistance against other pathogens needs to be further investigated. Besides, the mechanisms of BTH or BABA-induced plant disease resistance are complicated and dependent on the systems of the plant-pathogen interaction. For example, BTH can induce the plant disease resistance against B. cinerea by modifying the amino acid profile in grape [55]. BABA can induce the plant disease resistance against Plasmopara viticola by enhancing the callose formation and JA signaling or by the accumulation of lignin in grape plants [24,56]. Both BTH and BABA can induce the plant disease resistance against the Pst DC3000, mainly by activating the SA signaling pathway, such as the increased accumulation of SA and PR proteins [19,23]. However, in the present study, we found that OX activated the plant disease resistance against the Pst DC3000 by increasing the accumulation of both SA and JA and their responsive genes. Whether the OX-induced plant disease resistance is dependent on both SA and JA signaling pathways needs to be further studied.
In summary, in this study, we discovered that OX was a novel chemical inducer to activate the plant disease resistance against the Pst DC3000 in Arabidopsis by enhancing the callose deposition, H2O2 accumulation, and SA and JA production and related signaling pathways. Future research can be carried out to investigate the potential and associated mechanisms of OX as an important plant disease resistance inducer against other plant pathogens, such as bacteria, fungi, oomycetes, and viruses in different plant species. Such research will facilitate our understanding of the mechanism of the induced plant disease resistance and its application in agriculture to enhance plant health against diverse pathogen infections.
4. Materials and Methods
4.1. Plant Growth Conditions
Wild-type Arabidopsis thaliana (Col-0) plants and tobacco (Nicotiana benthamiana) plants were cultured in a growth room at 22 °C with 10 h light/14 h darkness for Arabidopsis thaliana (Col-0) and 16 h light/8 h darkness for tobacco, respectively. Tomato (Solanum lycopersicum) plants (cv. OH88119) were cultivated in a greenhouse at room temperature with 12 h light/12 h darkness. The pathogen inoculation experiments were conducted 4–5 weeks after the transplanting.
4.2. The OX Treatment, Pst DC3000 Infiltration, and Bacteria Growth Assay
OX, from DuPont Crop Protection (Wilmington, DE, USA), was dissolved in DMSO for a stocking solution at 4 × 104 μg/mL. The stocking solution was 1000 times diluted in water for a final concentration of 40 μg/mL. To evaluate the potential role of OX in activating the plant disease resistance against the pathogen Pst DC3000 infection, the Arabidopsis, tobacco, and tomato plants were sprayed with OX solution (40 μg/mL) or mock (water containing the same amount of DMSO) on leaves firstly. Two days after the spray treatment, the leaves were infiltrated with 10 mM MgCl2 containing the Pst DC3000 using a 1 mL syringe. The bacteria concentration was 1 × 105 CFU/mL (OD600 = 0.0002). Another test for the OX-induced plant disease resistance in Arabidopsis was through the treatment of the local leaves. For example, the lower leaves of Arabidopsis plants were infiltrated with the OX solution (40 μg/mL) or mock firstly. Two days later, the upper three or four leaves were infiltrated with bacterial broth, as described above. Three days after the infiltration with the Pst DC3000, three leaf discs were collected from the bacteria infiltrated leaves as one sample for the bacteria growth assay [57]. Each treatment had at least three replicates, and the whole experiment was conducted three times with consistent results.
4.3. The Direct Inhibition Effect of OX against the Pst DC3000 by the in-Vitro Plate Assay
The direct inhibition effect of OX against the Pst DC3000 was performed by the in-vitro plate inhibition assay. King’s B agar amended with 40 µg/mL OX and the concentration of DMSO was limited to 0.1% (v/v). An equivalent concentration of DMSO was used for the negative controls. Bacterial suspension (100 µL, 5 × 103 CFU/mL) was uniformly plated on the agar surface. The colony number was counted after 2 days of darkness-incubation at 28 °C. Three replicates were prepared for each treatment, and the entire experiment was performed three times with consistent results.
4.4. The H2O2 Detection and Callose Deposition
The H2O2 was detected according to a previous report with a minor modification [58]. The mock or OX-treated Arabidopsis leaves were sliced into 5 mm diameter discs and incubated in the plastic plates containing the distilled water for 12 h. Three leaf discs were treated with water or 200 nM flg22 (GeneScript, Piscataway, NJ, USA) as the PAMP treatment in 200 μL buffer containing 20 μM luminol and 1 μg/mL horseradish peroxidase. Luminescence was continuously measured for 30 min by using the Glomax 20/20 single well luminometer (Promega, Madison ,WI, USA). Each treatment had at least three replicates and the whole experiment was conducted twice with the consistent results.
The callose deposition was measured based on a protocol reported by Lin Jin [40]. In brief, the mock or OX-treated Arabidopsis plants were infiltrated with 100 μM flg22 or water. The infiltrated leaves were stained for callose by 0.01% aniline blue (Cat #: 415049, Sigma-Aldrich, St. Louis, MO, USA) after 14–16 h after infiltration (hpi). The callose deposition was visualized by a Nikon Eclipse 80i epi-fluorescent microscope (Nikon, Tokyo, Japan) and further quantified by Image J software (http://rsbweb.nih.gov/ij/). Each treatment included six plants, and the whole experiment was conducted twice with consistent results.
4.5. Plant Hormone Extraction and Quantification
Plant hormones were extracted and detected according to the previous reports [59,60]. In brief, the mock or OX-treated Arabidopsis plants were infiltrated with buffer (10 mM MgCl2) or buffer containing the Pst DC3000 cells. The bacterial cell concentration was 5 × 105 Colony Forming Unit (CFU)/mL (OD600 = 0.001). Two days after infiltration, the leaf samples (approximately 110 mg fresh weight per sample) were collected and extracted with 400 μL extraction buffer containing 10% methanol and 1% acetic acid. Isotope labelled internal standards (d4-SA, d5-JA, and d6-ABA) were added at the beginning of the extraction. The amounts of the internal standards added were 1 ng of 2H6-ABA (d6-ABA, Toronto Research Chemicals, North York, ON, USA; part #: A110002), 15 ng 2H4-SA (d4-SA, CDN Isotopes, Pointe-Claire, QC, Canada, part #: D-1156), and 150 ng 2H5-JA (d5-JA, CDN Isotopes, Pointe-Claire, QC, Canada, part #D-6936). After the addition of the extraction buffer, the tubes were incubated on ice for 30 min and centrifuged at 4 °C (13,000 g, 10 min). The supernatant was collected and re-extracted. After two procedures of extraction with the extraction buffer, the final supernatant was collected and analyzed using UPLC/ESI/MS with the Thermo Fisher Ultimate 3000 system (Thermo Fisher, Waltham, MA, USA). The UPLC separation was carried out on a 3 μm C18 (100 mm × 2.0 mm) column (Waters company, Milford, MA, USA) at 35 °C. The mobile phase was set for a continuum gradient from (94.9% H2O: 5% CH3CN: 0.1% CHOOH) to (5% H2O: 94.9% CH3CN: 0.1% CHOOH) over 20 mins. The analysis of the compounds was based on Multiple Reaction Monitoring (MRM) of ion pairs for the labelled and endogenous hormones. Transition settings for SA, JA, and ABA were 2H4-SA 141 (97), SA 137 (93), 2H6-ABA 269 (159), ABA 263 (153), SA-Gly (the glycosylated derivative of salicylic acid) 299 (93), 2H5-JA 214 (61), JA 209 (59), and JA-Ile/Leu 322 (130). The daughter masses were denoted in the brackets listed above. Each treatment had five replicates.
4.6. RNA Extraction and Gene Expression Quantification
The total RNA of the Arabidopsis leaves was extracted using TRIzol Reagent (Invitrogen, Carlsbad, MA, USA) as the described protocol. First-strand cDNA was synthesized using the Applied Biosystems reverse transcription kit (Applied Biosystem, Waltham, MA, USA, catalog number: 4368814). Gene expression was quantified using the real-time qPCR with the CFX96 real-time PCR detection system (Bio-Rad, Hercules, CA, USA). Data was analyzed using the 2−∆Ct method. ACTIN was used as the internal reference gene. The primers used in this study were listed in Table S1.
Supplementary Materials
Supplementary materials can be found at https://www.mdpi.com/1422-0067/21/4/1223/s1. Figure S1: OX activated the plant disease resistance against the Pst DC3000 infection in tobacco (A) and tomato (B) plants. The tobacco or tomato plants were sprayed with OX (40 μg/mL) or mock (water with DMSO). The leaves were infiltrated with the Pst DC3000 (1 × 105 CFU/mL, OD600 = 0.0002) using a 1 mL syringe two days after the spray treatment. Three days after the pathogen inoculation, the bacterial growth was quantified by the plate assay. Significant differences between the OX-treated plants and the mock were indicated by the asterisks determined from the Student’s t-test (p < 0.05). Results shown (means ± SD) are from one of the three independent repeats with the consistent results. Table S1: Primers used for qPCR in this study.
Author Contributions
Conceptualization, Q.P., Z.W., X.L. and Y.X.; investigation, Q.P., Y.L., Z.Z. and W.L.; writing–original draft, Q.P.; writing–review & editing, Q.P., P.L., X.L. and Y.X. All authors have read and agreed to the published version of the manuscript.
Funding
This project is supported by the National Natural Science Foundation of China (31730075) to Xili Liu; the Hatch Project from USDA-NIFA-OHO01392, the Ohio Agricultural Research and Development Center (OARDC) Seed Grant OHOA1615, and the Ohio Agricultural Research and Development Center (OARDC) Seed Grant OHOA1591 to Ye Xia; and the China Scholarship Council Fellowship to Qin Peng (No.201806350107).
Acknowledgments
We thank DuPont Crop Protection for providing the oxathiapiprolin. We appreciate Arabidopsis Biological Resource Center (ABRC) for providing the Arabidopsis seeds used in this study. We also appreciate Matthew Bernier from Campus Chemical Instrument Center at The Ohio State University to help us with the development of the protocol for plant hormone analysis. We appreciate Michael Kelly from the Department of Plant Pathology at The Ohio State University for helping us with the plant growth in the growth room and greenhouse.
Conflicts of Interest
The authors declare no conflict of interest.
References
- Savary, S.; Willocquet, L.; Pethybridge, S.J.; Esker, P.; McRoberts, N.; Nelson, A. The global burden of pathogens and pests on major food crops. Nat. Ecol. Evol. 2019, 3, 430–439. [Google Scholar] [CrossRef] [PubMed]
- Jones, J.D.; Dangl, J.L. The plant immune system. Nature 2006, 444, 323–329. [Google Scholar] [CrossRef] [PubMed]
- Chisholm, S.T.; Coaker, G.; Day, B.; Staskawicz, B.J. Host-Microbe Interactions: Shaping the Evolution of the Plant Immune Response. Cell 2006, 124, 803–814. [Google Scholar] [CrossRef] [PubMed]
- Katagiri, F.; Tsuda, K. Understanding the Plant Immune System. Mol. Plant Microbe. Interact. 2010, 23, 1531–1536. [Google Scholar] [CrossRef] [PubMed]
- Bittel, P.; Robatzek, S. Microbe-associated molecular patterns (MAMPs) probe plant immunity. Curr. Opin. Plant Biol. 2007, 10, 335–341. [Google Scholar] [CrossRef]
- He, P.; Shan, L.; Sheen, J. Elicitation and suppression of microbe-associated molecular pattern-triggered immunity in plant-microbe interactions. Cell Microbiol. 2007, 9, 1385–1396. [Google Scholar] [CrossRef]
- Newman, M.A.; Sundelin, T.; Nielsen, J.T.; Erbs, G. MAMP (microbe-associated molecular pattern) triggered immunity in plants. Front. Plant Sci. 2013, 4, 139. [Google Scholar] [CrossRef]
- Conrath, U.; Beckers, G.J.M.; Flors, V.; García-Agustín, P.; Jakab, G.; Mauch, F.; Newman, M.-A.; Pieterse, C.M.J.; Poinssot, B.; Pozo, M.J.; et al. Priming: Getting Ready for Battle. Mol. Plant Microbe. Interact. 2006, 19, 1062–1071. [Google Scholar] [CrossRef]
- Ryals, J.; Uknes, S.; Ward, E. Systemic Acquired Resistance. Plant Physiol. 1994, 104, 1109–1112. [Google Scholar] [CrossRef]
- Ryals, J.A.; Neuenschwander, U.H.; Willits, M.G.; Molina, A.; Steiner, H.Y.; Hunt, M.D. Systemic Acquired Resistance. Plant Cell 1996, 8, 1809–1819. [Google Scholar] [CrossRef]
- Sticher, L.; Mauch-Mani, B.; Métraux, J. SYSTEMIC ACQUIRED RESISTANCE. Annu. Rev. Phytopathol. 1997, 35, 235–270. [Google Scholar] [CrossRef] [PubMed]
- Durrant, W.E.; Dong, X. SYSTEMIC ACQUIRED RESISTANCE. Annu. Rev. Phytopathol. 2004, 42, 185–209. [Google Scholar] [CrossRef] [PubMed]
- Cameron, R.K.; Paiva, N.L.; Lamb, C.J.; Dixon, R.A. Accumulation of salicylic acid and PR-1 gene transcripts in relation to the systemic acquired resistance (SAR) response induced by Pseudomonas syringae pv. tomato in Arabidopsis. Physiol. Mol. Plant Pathol. 1999, 55, 121–130. [Google Scholar] [CrossRef]
- Kohler, A.; Schwindling, S.; Conrath, U. Benzothiadiazole-Induced Priming for Potentiated Responses to Pathogen Infection, Wounding, and Infiltration of Water into Leaves Requires the NPR1/NIM1 Gene in Arabidopsis. Plant Physiol. 2002, 128, 1046. [Google Scholar] [CrossRef] [PubMed]
- Barilli, E.; Sillero, J.C.; Rubiales, D. Induction of Systemic Acquired Resistance in Pea against Rust (Uromyces pisi) by Exogenous Application of Biotic and Abiotic Inducers. J. Phytopathol. 2010, 158, 30–34. [Google Scholar] [CrossRef]
- White, R.F. Acetylsalicylic acid (aspirin) induces resistance to tobacco mosaic virus in tobacco. Virology 1979, 99, 410–412. [Google Scholar] [CrossRef]
- Vernooij, B.; Friedrich, L.; Morse, A.; Reist, R.; Kolditz-Jawhar, R.; Ward, E.; Uknes, S.; Kessmann, H.; Ryals, J. Salicylic Acid Is Not the Translocated Signal Responsible for Inducing Systemic Acquired Resistance but Is Required in Signal Transduction. Plant Cell 1994, 6, 959. [Google Scholar] [CrossRef]
- Görlach, J.; Volrath, S.; Knauf-Beiter, G.; Hengy, G.; Beckhove, U.; Kogel, K.H.; Oostendorp, M.; Staub, T.; Ward, E.; Kessmann, H.; et al. Benzothiadiazole, a novel class of inducers of systemic acquired resistance, activates gene expression and disease resistance in wheat. Plant Cell 1996, 8, 629. [Google Scholar]
- Lawton, K.A.; Friedrich, L.; Hunt, M.; Weymann, K.; Delaney, T.; Kessmann, H.; Staub, T.; Ryals, J. Benzothiadiazole induces disease resistance in Arabidopsis by activation of the systemic acquired resistance signal transduction pathway. Plant J. 1996, 10, 71–82. [Google Scholar] [CrossRef]
- Benhamou, N.; Bélanger, R.R. Benzothiadiazole-Mediated Induced Resistance to Fusarium oxysporum f. sp. radicis-lycopersici in Tomato. Plant Physiol. 1998, 118, 1203. [Google Scholar] [CrossRef]
- Iriti, M.; Rossoni, M.; Borgo, M.; Faoro, F. Benzothiadiazole Enhances Resveratrol and Anthocyanin Biosynthesis in Grapevine, Meanwhile Improving Resistance to Botrytis cinerea. J. Agric. Food Chem. 2004, 52, 4406–4413. [Google Scholar] [CrossRef] [PubMed]
- Zimmerli, L.; Métraux, J.-P.; Mauch-Mani, B. β-Aminobutyric Acid-Induced Protection of Arabidopsis against the Necrotrophic Fungus Botrytis cinerea. Plant Physiol. 2001, 126, 517. [Google Scholar] [CrossRef] [PubMed]
- Zimmerli, L.; Jakab, G.; Métraux, J.-P.; Mauch-Mani, B. Potentiation of pathogen-specific defense mechanisms in Arabidopsis by β-aminobutyric acid. Proc. Natl. Acad. Sci. USA 2000, 97, 12920. [Google Scholar] [CrossRef] [PubMed]
- Hamiduzzaman, M.M.; Jakab, G.; Barnavon, L.; Neuhaus, J.M.; Mauch-Mani, B. beta-Aminobutyric acid-induced resistance against downy mildew in grapevine acts through the potentiation of callose formation and jasmonic acid signaling. Mol. Plant Microbe Interact. 2005, 18, 819–829. [Google Scholar] [CrossRef] [PubMed]
- Li, T.; Fan, P.; Yun, Z.; Jiang, G.; Zhang, Z.; Jiang, Y. β-Aminobutyric Acid Priming Acquisition and Defense Response of Mango Fruit to Colletotrichum gloeosporioides Infection Based on Quantitative Proteomics. Cells 2019, 8, 1029. [Google Scholar] [CrossRef] [PubMed]
- Cordier, C.; Pozo, M.J.; Barea, J.M.; Gianinazzi, S.; Gianinazzi-Pearson, V. Cell Defense Responses Associated with Localized and Systemic Resistance to Phytophthora parasitica Induced in Tomato by an Arbuscular Mycorrhizal Fungus. Mol. Plant Microbe Interact. 1998, 11, 1017–1028. [Google Scholar] [CrossRef]
- Pozo, M.J.; Cordier, C.; Dumas-Gaudot, E.; Gianinazzi, S.; Barea, J.M.; Azcón-Aguilar, C. Localized versus systemic effect of arbuscular mycorrhizal fungi on defence responses to Phytophthora infection in tomato plants. J. Exp. Bot. 2002, 53, 525–534. [Google Scholar] [CrossRef]
- Xin, X.-F.; Kvitko, B.; He, S.Y. Pseudomonas syringae: What it takes to be a pathogen. Nat. Rev. Microbiol. 2018, 16, 316. [Google Scholar] [CrossRef]
- Hirano, S.S.; Upper, C.D. Bacteria in the Leaf Ecosystem with Emphasis on Pseudomonas syringae—A Pathogen, Ice Nucleus, and Epiphyte. Microbiol. Mol. Biol. Rev. 2000, 64, 624–653. [Google Scholar] [CrossRef]
- Cuppels, D.A. Generation and characterization of Tn5 insertion mutations in Pseudomonas syringae pv. tomato. Appl. Environ. Microbiol. 1986, 51, 323–327. [Google Scholar] [CrossRef]
- Xin, X.F.; He, S.Y. Pseudomonas syringae pv. tomato DC3000: A model pathogen for probing disease susceptibility and hormone signaling in plants. Annu. Rev. Phytopathol. 2013, 51, 473–498. [Google Scholar] [CrossRef] [PubMed]
- Pasteris, R.; Hanagan, M.; Shapiro, R.J.I. Geneva: World Intellectual Property Organization, Fungicidal Azocyclic Amides. Patent Application No. WO2008013622, 31 January 2008. [Google Scholar]
- Pasteris, R.J.; Hanagan, M.A.; Bisaha, J.J.; Finkelstein, B.L.; Hoffman, L.E.; Gregory, V.; Andreassi, J.L.; Sweigard, J.A.; Klyashchitsky, B.A.; Henry, Y.T.; et al. Discovery of oxathiapiprolin, a new oomycete fungicide that targets an oxysterol binding protein. Bioorgan. Med. Chem. 2016, 24, 354–361. [Google Scholar]
- Ji, P.; Csinos, A.S.; Hickman, L.L.; Hargett, U. Efficacy and application methods of oxathiapiprolin for management of black shank on tobacco. Plant Dis. 2014, 98, 1551–1554. [Google Scholar] [CrossRef] [PubMed]
- Cohen, Y. The novel oomycide oxathiapiprolin inhibits all stages in the asexual life cycle of Pseudoperonospora cubensis-causal agent of cucurbit downy mildew. PLoS ONE 2015, 10, e0140015. [Google Scholar] [CrossRef] [PubMed]
- Ji, P.; Csinos, A.S. Effect of oxathiapiprolin on asexual life stages of Phytophthora capsici and disease development on vegetables. Ann. Appl. Biol. 2015, 166, 229–235. [Google Scholar] [CrossRef]
- Miao, J.; Dong, X.; Lin, D.; Wang, Q.; Liu, P.; Chen, F.; Du, Y.; Liu, X. Activity of the novel fungicide oxathiapiprolin against plant-pathogenic oomycetes. Pest. Manag. Sci. 2016, 72, 1572–1577. [Google Scholar] [CrossRef] [PubMed]
- Torres, M.A.; Dangl, J.L.; Jones, J.D. Arabidopsis gp91phox homologues AtrbohD and AtrbohF are required for accumulation of reactive oxygen intermediates in the plant defense response. Proc. Natl. Acad. Sci. USA 2002, 99, 517–522. [Google Scholar] [CrossRef]
- Luna, E.; Pastor, V.; Robert, J.; Flors, V.; Mauch-Mani, B.; Ton, J. Callose deposition: A multifaceted plant defense response. Mol. Plant 2011, 24, 183–193. [Google Scholar] [CrossRef]
- Jin, L.; Mackey, D.M. Measuring Callose Deposition, an Indicator of Cell Wall Reinforcement, During Bacterial Infection in Arabidopsis. Methods Mol. Biol. 2017, 1578, 195–205. [Google Scholar]
- Penninckx, I.A.M.A.; Thomma, B.P.H.J.; Buchala, A.; Métraux, J.-P.; Broekaert, W.F. Concomitant Activation of Jasmonate and Ethylene Response Pathways Is Required for Induction of a Plant Defensin Gene in Arabidopsis. Plant Cell 1998, 10, 2103. [Google Scholar] [CrossRef]
- Quirino, B.F.; Bent, A.F. Deciphering host resistance and pathogen virulence: The Arabidopsis/Pseudomonas interaction as a model. Mol. Plant Pathol. 2003, 4, 517–530. [Google Scholar] [CrossRef] [PubMed]
- Qi, J.; Wang, J.; Gong, Z.; Zhou, J.-M. Apoplastic ROS signaling in plant immunity. Curr. Opin. Plant Biol. 2017, 38, 92–100. [Google Scholar] [CrossRef]
- Hirt, H. Aquaporins Link ROS Signaling to Plant Immunity. Plant Physiol. 2016, 171, 1540. [Google Scholar] [CrossRef] [PubMed]
- Kadota, Y.; Shirasu, K.; Zipfel, C. Regulation of the NADPH Oxidase RBOHD During Plant Immunity. Plant Cell Physiol. 2015, 56, 1472–1480. [Google Scholar] [CrossRef] [PubMed]
- Malinovsky, F.G.; Fangel, J.U.; Willats, W.G. The role of the cell wall in plant immunity. Front. Plant Sci. 2014, 5, 178. [Google Scholar] [CrossRef] [PubMed]
- Hückelhoven, R. Cell Wall–Associated Mechanisms of Disease Resistance and Susceptibility. Annu. Rev. Phytopathol. 2007, 45, 101–127. [Google Scholar] [CrossRef]
- Verma, V.; Ravindran, P.; Kumar, P.P. Plant hormone-mediated regulation of stress responses. BMC Plant Biol. 2016, 16, 86. [Google Scholar] [CrossRef]
- Bari, R.; Jones, J.D.G. Role of plant hormones in plant defence responses. Plant Mol. Biol. 2009, 69, 473–488. [Google Scholar] [CrossRef]
- Spoel, S.H.; Dong, X. microbe, Making sense of hormone crosstalk during plant immune responses. Cell Host Microbe 2008, 3, 348–351. [Google Scholar] [CrossRef]
- Kunkel, B.N.; Brooks, D.M. Cross talk between signaling pathways in pathogen defense. Curr. Opin. Plant Biol. 2002, 5, 325–331. [Google Scholar] [CrossRef]
- Beckers, G.J.M.; Spoel, S.H. Fine-Tuning Plant Defence Signalling: Salicylate versus Jasmonate. Plant Biol. (Stuttg) 2006, 8, 1–10. [Google Scholar] [CrossRef] [PubMed]
- Jia, X.; Zeng, H.; Wang, W.; Zhang, F.; Yin, H. Chitosan Oligosaccharide Induces Resistance to Pseudomonas syringae pv. tomato DC3000 in Arabidopsis thaliana by Activating Both Salicylic Acid- and Jasmonic Acid-Mediated Pathways. Mol. Plant Microbe Interact. 2018, 31, 1271–1279. [Google Scholar] [CrossRef]
- Melotto, M.; Underwood, W.; Koczan, J.; Nomura, K.; He, S.Y. Plant Stomata Function in Innate Immunity against Bacterial Invasion. Cell 2006, 126, 969–980. [Google Scholar] [CrossRef] [PubMed]
- Iriti, M.; Rossoni, M.; Borgo, M.; Ferrara, L.; Faoro, F. Induction of Resistance to Gray Mold with Benzothiadiazole Modifies Amino Acid Profile and Increases Proanthocyanidins in Grape: Primary versus Secondary Metabolism. J. Agric. Food Chem. 2005, 53, 9133–9139. [Google Scholar] [CrossRef] [PubMed]
- Cohen, Y.R. β-Aminobutyric Acid-Induced Resistance Against Plant Pathogens. Plant Dis. 2002, 86, 448–457. [Google Scholar] [CrossRef] [PubMed]
- Zipfel, C.; Robatzek, S.; Navarro, L.; Oakeley, E.J.; Jones, J.D.G.; Felix, G.; Boller, T. Bacterial disease resistance in Arabidopsis through flagellin perception. Nature 2004, 428, 764–767. [Google Scholar] [CrossRef]
- Zhang, J.; Li, W.; Xiang, T.; Liu, Z.; Laluk, K.; Ding, X.; Zou, Y.; Gao, M.; Zhang, X.; Chen, S.; et al. Receptor-like cytoplasmic kinases integrate signaling from multiple plant immune receptors and are targeted by a Pseudomonas syringae effector. Cell Host Microbe 2010, 7, 290–301. [Google Scholar] [CrossRef]
- Wang, M.; Rui, L.; Yan, H.; Shi, H.; Zhao, W.; Lin, J.E.; Zhang, K.; Blakeslee, J.J.; Mackey, D.; Tang, D.; et al. The major leaf ferredoxin Fd2 regulates plant innate immunity in Arabidopsis. Mol. Plant. Pathol. 2018, 19, 1377–1390. [Google Scholar] [CrossRef]
- Forcat, S.; Bennett, M.H.; Mansfield, J.W.; Grant, M.R. A rapid and robust method for simultaneously measuring changes in the phytohormones ABA, JA and SA in plants following biotic and abiotic stress. Plant Methods 2008, 4, 16. [Google Scholar] [CrossRef]
© 2020 by the authors. Licensee MDPI, Basel, Switzerland. This article is an open access article distributed under the terms and conditions of the Creative Commons Attribution (CC BY) license (http://creativecommons.org/licenses/by/4.0/).